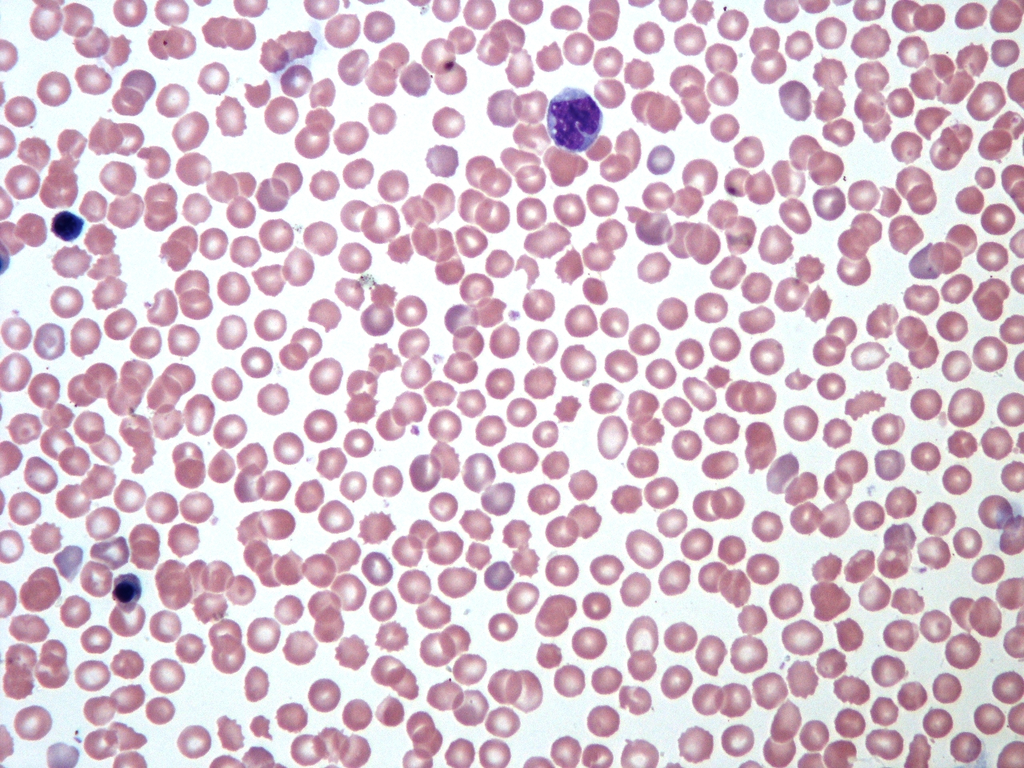
blood_smear__wright__8d119409f041
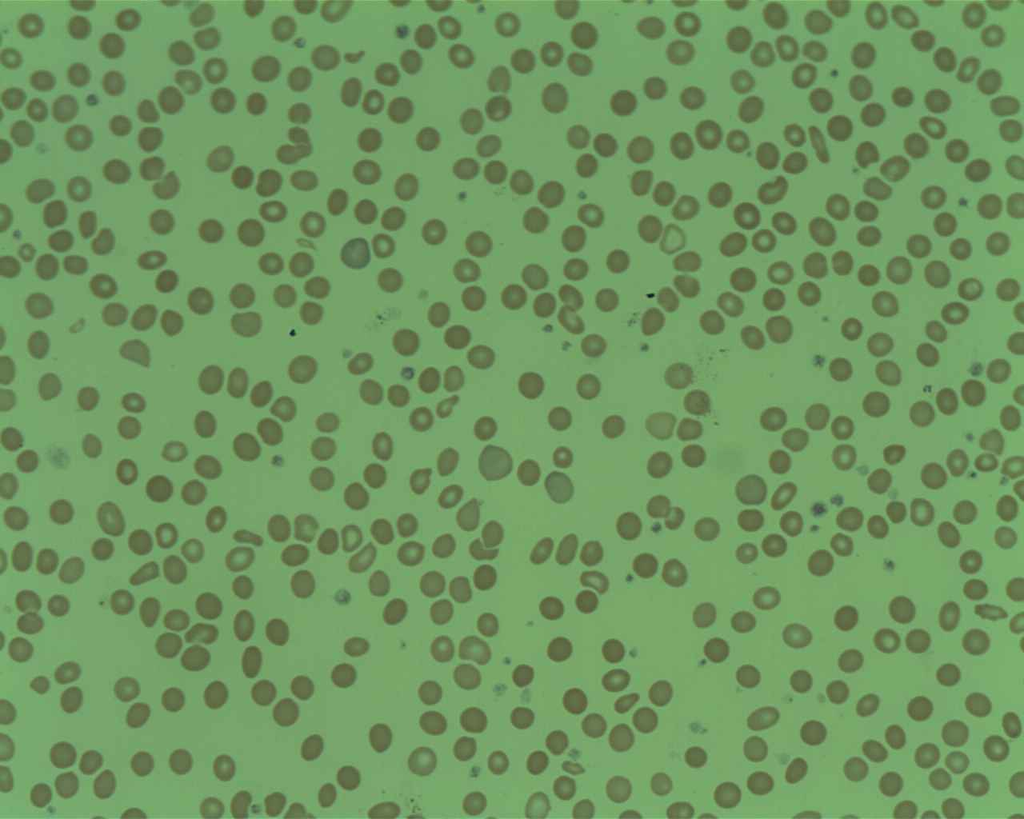
blood_smear__wright__b54ba99a8689
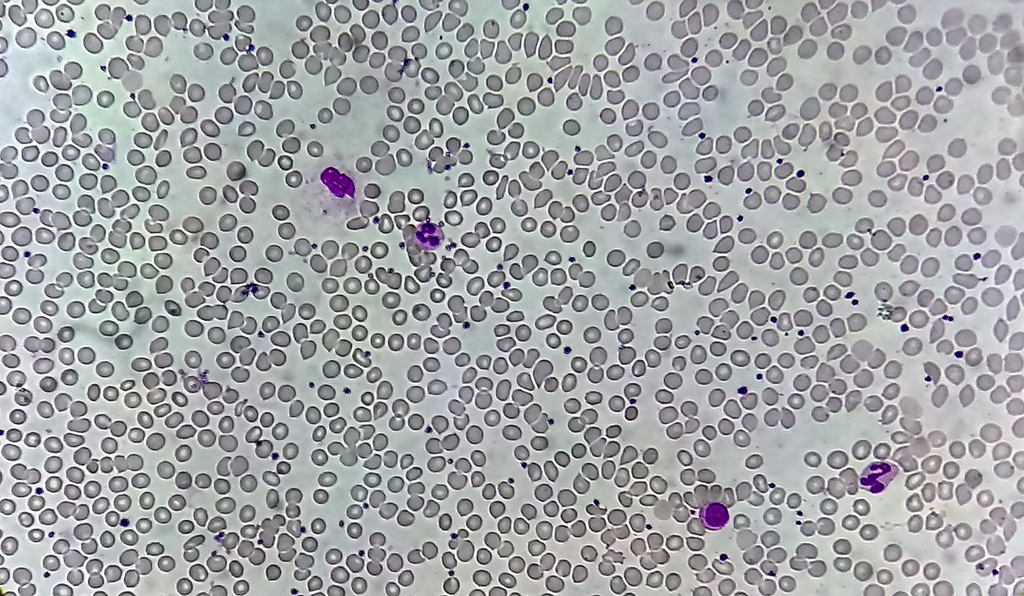
blood_smear__wright__35d9e1d51cef
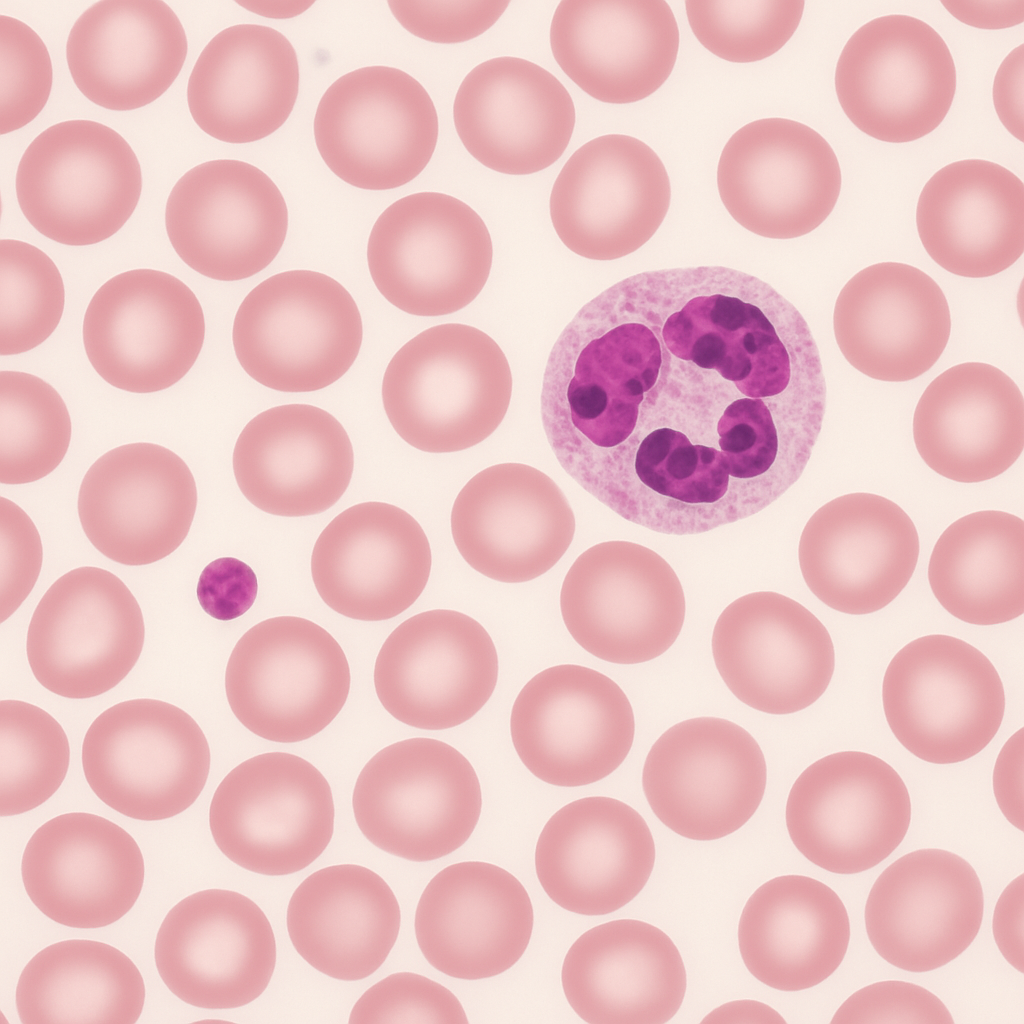
ai_peripheral_blood_smear__wright__0159223ecd34
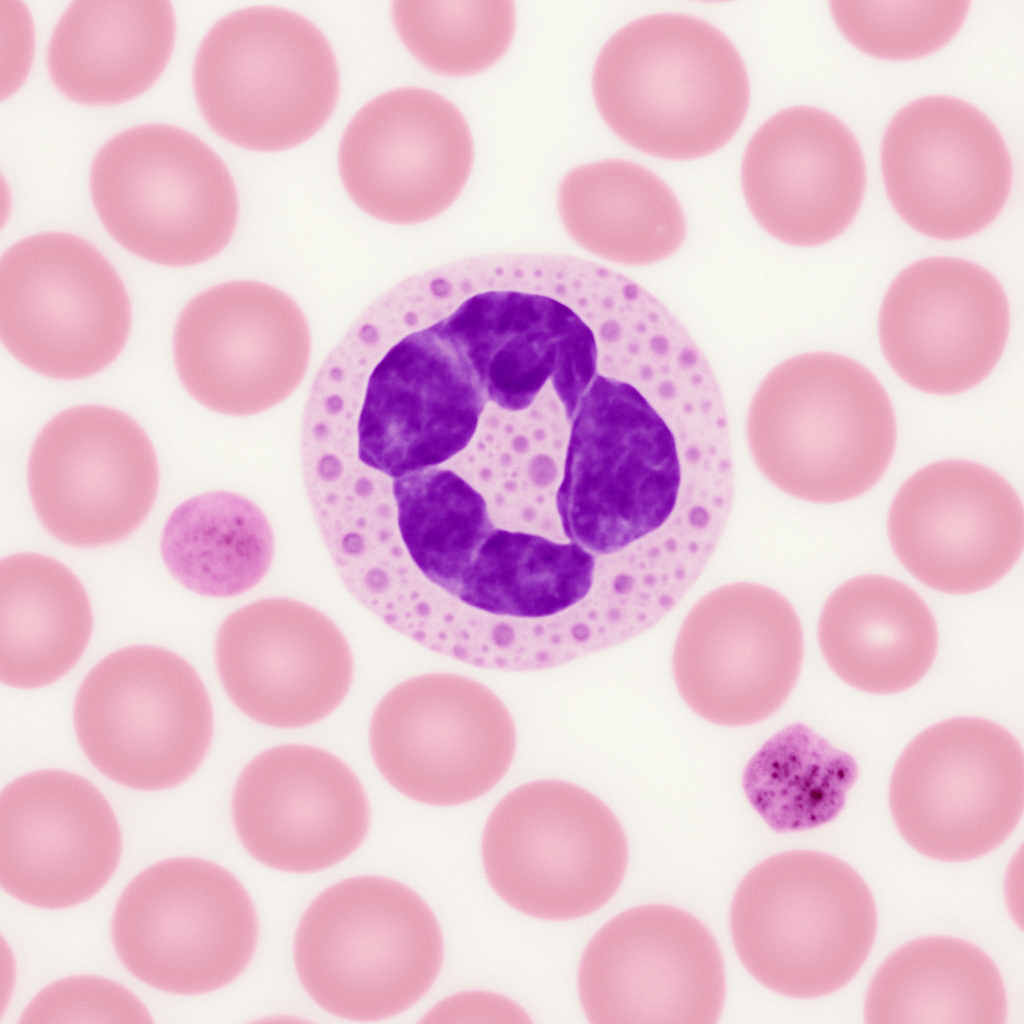
ai_peripheral_blood_smear__wright__beb540b38509

Specimen Image Library

Wright-stained peripheral blood film showing red blood cells, white blood cells, and platelets























Formalin-fixed paraffin-embedded tissue section with hematoxylin and eosin staining





























Heat-fixed bacterial smear with Gram staining showing gram-positive and gram-negative organisms



Golgi-stained brain tissue section showing neuronal morphology



Transverse section of skeletal muscle showing fiber bundles and striations



Cultured HeLa cells (cervical adenocarcinoma) in monolayer



Papanicolaou-stained cervical smear for screening



Centrifuged urine sediment showing casts, crystals, and cells



Transverse section of dicot leaf showing epidermis, mesophyll, and vascular bundles



Gold nanoparticles (50 nm) on carbon grid for TEM imaging
Silicon wafer cross-section showing transistor gate structures


Acetolyzed mixed pollen from flowering plants




Wright-Giemsa stained bone marrow aspirate smear





Negatively stained virus particles on carbon-coated copper grid


Designed DNA origami structures deposited on mica for AFM imaging

AI-generated peripheral blood smear image set spanning the full range of microscopy...



Human chromosome preparations for cytogenetic analysis including G-banded karyotypes,...












AI-generated brain tissue image set spanning the full range of microscopy...